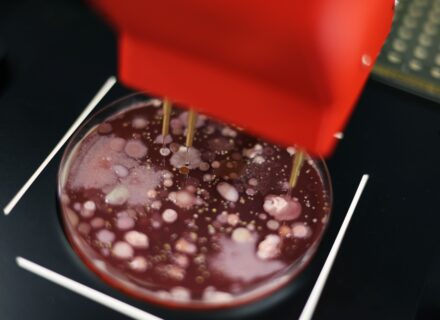
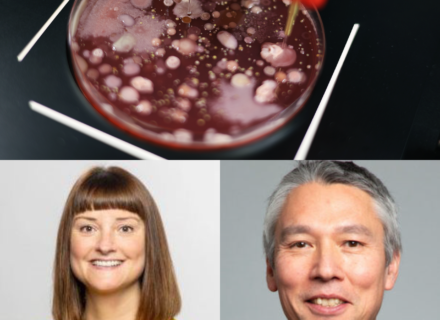

PIXL Max
Faster, Smarter Colony Picking

| Single colony picking |
|
| Integrability |
|
| High-throughput screening |
|
| Phenotype filtering |
|
PIXL
Standalone Colony Picking

| Single colony picking |
|
| Integrability |
|
| High-throughput screening |
|
| Phenotype filtering |
|
PIXL Dark
Integration-ready Colony Picking

| Single colony picking |
|
| Integrability |
|
| High-throughput screening |
|
| Phenotype filtering |
|